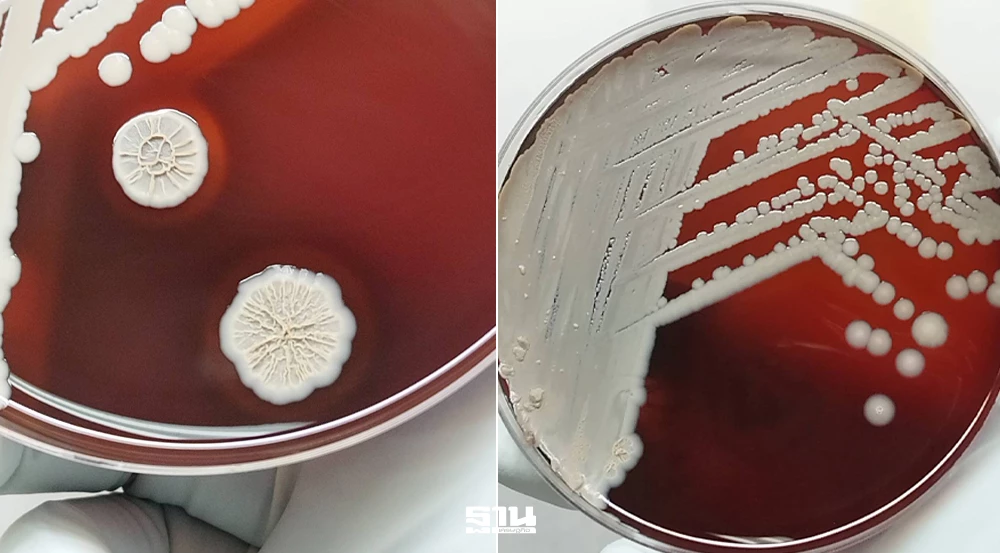
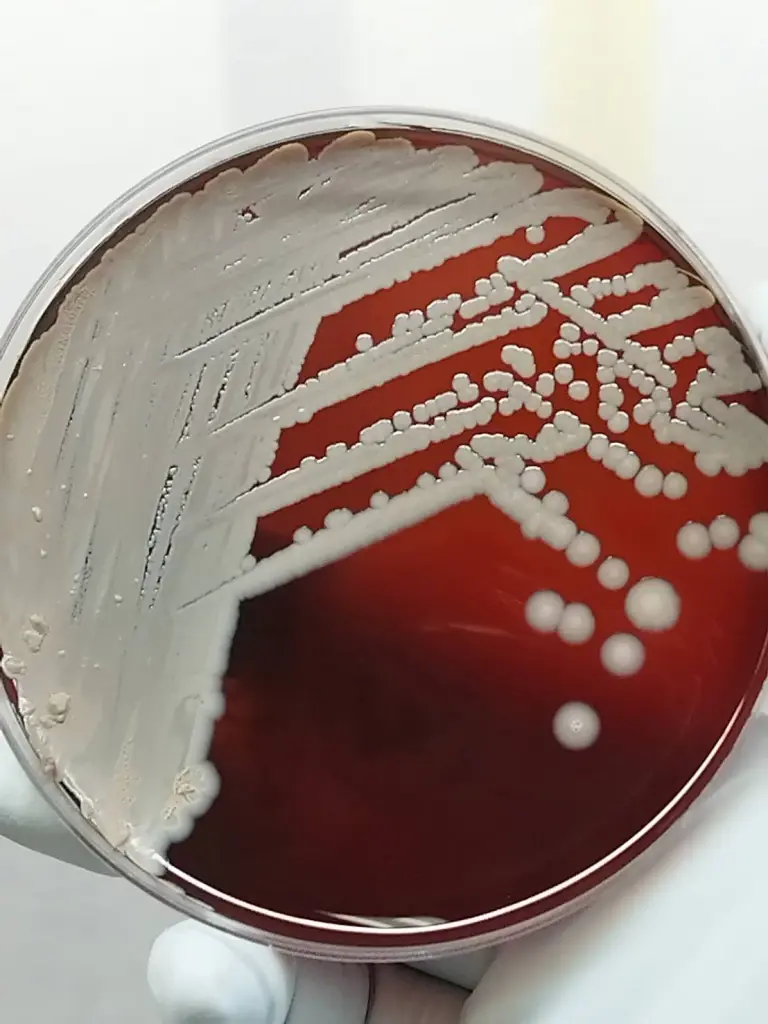
คนไทยป่วย โรคไข้ดิน พุ่ง กรมวิทย์ ชูตรวจแล็บครบวงจร รู้ผลไว ช่วยรักษาทันท่วงที

คนไทยป่วย โรคไข้ดิน พุ่ง กรมวิทย์ ชูตรวจแล็บครบวงจร รู้ผลไว ช่วยรักษาทันท่วงที
กรมวิทยาศาสตร์การแพทย์ เผยสถิติโรคเมลิออยโดสิส โรคไข้ดิน แนวโน้มมีผู้ติดเชื้อเพิ่มสูงขึ้นเมื่อเทียบกับ 4 ปีก่อน เผย ความพร้อมตรวจเชื้อก่อโรคแบบครบวงจร วินิจฉัย รักษาผู้ป่วยอย่างทันท่วงที พร้อมเฝ้าระวังเชื้อสายพันธุ์ดื้อยาต้านจุลชีพ
KEY
POINTS
- กรมวิทยาศาสตร์การแพทย์เปิดเผยข้อมูลผู้ป่วยโรคไข้ดิน หรือเมลิออยโดสิส มีแนวโน้มเพิ่มสูงขึ้นอย่างชัดเจน
- พร้อมให้บริการตรวจวินิจฉัยเชื้อแบบครบวงจรด้วยเทคโนโลยีชีวโมเลกุล (real-time PCR) ที่ให้ผลรวดเร็วและแม่นยำ
- การวินิจฉัยที่รวดเร็วช่วยให้แพทย์สามารถรักษาผู้ป่วยได้ทันท่วงที ลดความรุนแรงของโรคและป้องกันการเสียชีวิต
22 เมษายน 2569 กรมวิทยาศาสตร์การแพทย์ กระทรวงสาธารณสุข เปิดเผยสถานการณ์โรคเมลิออยโดสิส หรือโรคไข้ดิน จากข้อมูลทางห้องปฏิบัติการพบแนวโน้มผู้ติดเชื้อเพิ่มขึ้น พร้อมให้บริการตรวจวินิจฉัยด้วยวิธีทางชีวโมเลกุล เพื่อสนับสนุนการวินิจฉัยและรักษาผู้ป่วยได้อย่างทันท่วงที และการเฝ้าระวังสายพันธุ์ดื้อยาต้านจุลชีพ
โดย ดร.นพ.สราวุฒิ บุญสุข อธิบดีกรมวิทยาศาสตร์การแพทย์ กล่าวว่า จากกรณีพบผู้เสียชีวิตจากโรคเมลิออยโดสิส กรมวิทยาศาสตร์การแพทย์ในฐานะห้องปฏิบัติการอ้างอิงของประเทศมีความพร้อมในการตรวจเชื้อก่อโรคโดยให้บริการตรวจวินิจฉัยแบบครบวงจร ประกอบด้วย การตรวจรวดเร็วทางซีรัมวิทยาเพื่อตรวจหาระดับแอนติบอดีในเลือด การเพาะเลี้ยงเชื้อ การตรวจสารพันธุกรรมด้วยวิธี real-time PCR การตรวจจีโนมเชื้อก่อโรค และการทดสอบความไวต่อยาต้านจุลชีพ โดยแพทย์จะใช้ผลตรวจร่วมกับอาการและประวัติของผู้ป่วยในการวินิจฉัยโรคและการรักษาผู้ป่วย
ดร.นพ.สราวุฒิ อธิบดีกรมวิทยาศาสตร์การแพทย์ กล่าวเพิ่มเติมว่า ในปีงบประมาณ 2568 สถาบันวิจัยวิทยาศาสตร์สาธารณสุข ได้รับตัวอย่างผู้ป่วยสงสัยโรคเมลิออยโดสิส จำนวน 177 ตัวอย่าง พบการติดเชื้อ 38 ตัวอย่าง คิดเป็นร้อยละ 21.5 โดยเป็นเพศชาย 110 ตัวอย่าง พบติดเชื้อ 23 ตัวอย่าง (ร้อยละ 20.9) และเพศหญิง 67 ตัวอย่าง พบติดเชื้อ 15 ตัวอย่าง (ร้อยละ 23.4)
เมื่อเปรียบเทียบข้อมูลย้อนหลัง 4 ปี (พ.ศ. 2564–2567) พบว่า มีจำนวนตัวอย่างส่งตรวจรวม 542 ตัวอย่าง และพบการติดเชื้อ 40 ตัวอย่าง คิดเป็นร้อยละ 7.4 สะท้อนให้เห็นว่าอุบัติการณ์ของโรคเมลิออยโดสิสมีแนวโน้มเพิ่มสูงขึ้นอย่างชัดเจน

นอกจากนี้กรมวิทยาศาสตร์การแพทย์ยังมีศักยภาพในการตรวจวินิจฉัยด้วยวิธี real-time PCR จากสิ่งส่งตรวจโดยตรง เช่น เลือด serum plasma และขวด hemoculture ซึ่งช่วยเพิ่มความรวดเร็วและความแม่นยำในการยืนยันผลทางห้องปฏิบัติการ อีกทั้งมีการตรวจวิเคราะห์โดยไม่คิดค่าใช้จ่ายในกรณีตรวจยืนยันเชื้อก่อโรคด้วยการวิเคราะห์จีโนม โดยเฉพาะในเชื้อที่อาจจำแนกผิดพลาดหรือสายพันธุ์ใกล้เคียงอื่นๆ และมีการเฝ้าระวังสายพันธุ์ดื้อยา ด้วยการทดสอบความไวต่อยาต้านจุลชีพและการศึกษายีนดื้อยา
ดร.นพ.สราวุฒิ อธิบดีกรมวิทยาศาสตร์การแพทย์ กล่าวย้ำว่า โรคเมลิออยโดสิส เป็นโรคติดเชื้อแบคทีเรีย Burkholderia pseudomallei ที่พบในดินและน้ำโดยมักพบการระบาดในช่วงฤดูฝน และสามารถพบได้ในทุกภูมิภาคของประเทศไทย เชื้อสามารถเข้าสู่ร่างกายผ่านบาดแผล การสูดดมฝุ่นดิน หรือการดื่มน้ำที่ปนเปื้อน อาการมีตั้งแต่ไข้สูง หายใจลำบาก แน่นหน้าอก ไปจนถึงมีแผลบวมแดงหรือฝีหนอง และหากเชื้อเข้าสู่กระแสเลือด อาจทำให้เกิดภาวะติดเชื้อรุนแรงและเสียชีวิตได้
อย่างไรก็ตาม โรคนี้สามารถรักษาให้หายได้ หากได้รับการวินิจฉัยและรักษาอย่างรวดเร็ว ดังนั้น ประชาชนที่มีความเสี่ยง หากมีอาการผิดปกติ เช่น มีไข้สูงต่อเนื่อง หรือมีประวัติสัมผัสดินและน้ำ ควรรีบพบแพทย์โดยเร็ว เพื่อป้องกันภาวะแทรกซ้อนที่รุนแรง และตรวจยืนยันสำหรับการรักษาระยะต่อเนื่องเพื่อป้องกันการกลับเป็นซ้ำ
สำหรับสถานพยาบาลที่ต้องการส่งตรวจวินิจฉัยโรคเมลิออยโดสิสทางห้องปฏิบัติการ หรือสอบถามข้อมูลเพิ่มเติม สามารถติดต่อศูนย์ประสานการตรวจวิเคราะห์และเฝ้าระวังโรคทางห้องปฏิบัติการ สถาบันวิจัยวิทยาศาสตร์สาธารณสุข กรมวิทยาศาสตร์การแพทย์ หรือประสานงานส่งต่อตัวอย่างได้ที่ศูนย์วิทยาศาสตร์การแพทย์ในพื้นที่ได้